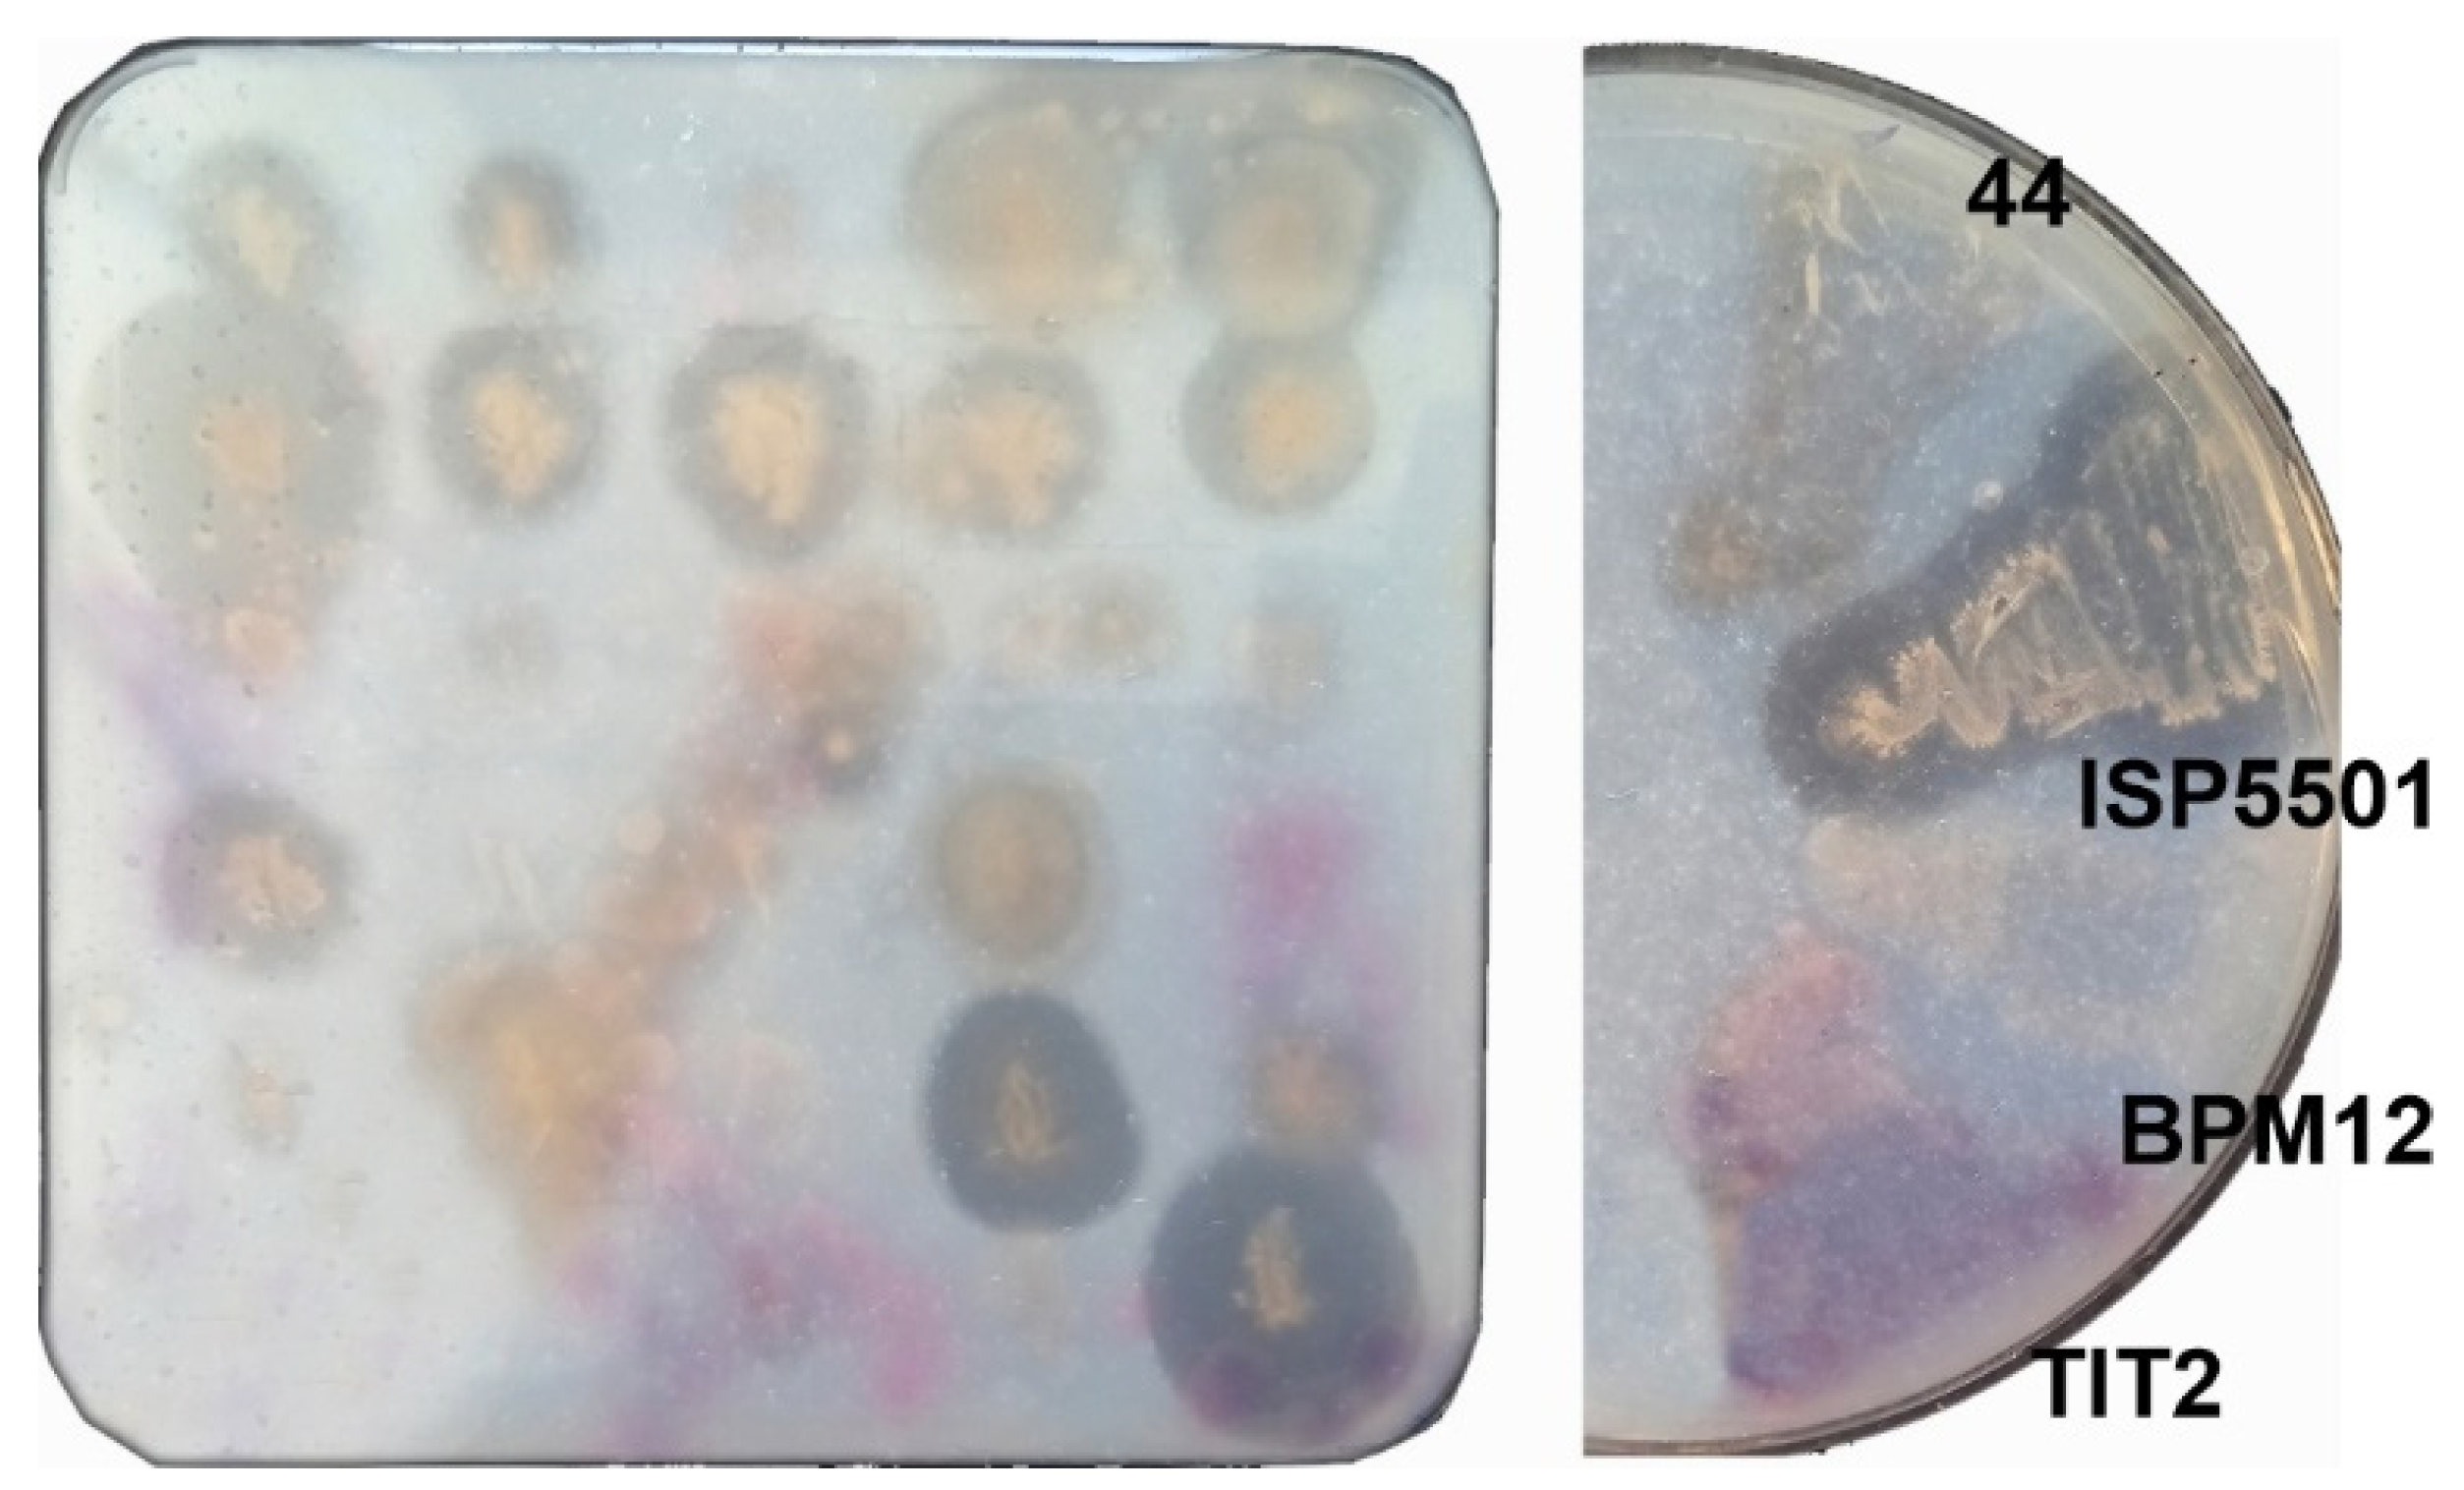
Catalysts 13 00278 g003 Catalysts 13 00278 g003

Set of Small Molecule Polyurethane (PU) Model Substrates: Ecotoxicity Evaluation and Identification of PU Degrading Biocatalysts
Abstract
1. Introduction
2. Results and Discussion
2.1. PU-Model Compounds Synthesis and Characterization
2.2. Cyto- and Ecotoxicity of the PU-Model Compounds
2.3. Degradation of PU Model Substrates by Known Esterases and Proteases
2.4. Identification of New PU-Degrading Biocatalysts
2.5. PU Polymer Degradation by A. mediterranei ISP5501
3. Conclusions
4. Materials and Methods
4.1. Reagents
4.2. PU Model Compounds Synthesis
4.3. Ecotoxicity Assessment of PU Model Compounds
4.3.1. Cytotoxicity Evaluation (MTT Assay)
4.3.2. Aliivibrio Fischeri Toxicity Tests
4.3.3. In Vivo Toxicity on Caenorhabditis Elegans
4.4. Recombinant Proteins and Enzymatic Degradation of PU Model Substrates
4.5. Screening and Identification of Microorganisms
4.6. Whole-Cell Biocatalytic Reactions and Mass Spectrometry Analysis of Degradation Products
4.7. Degradation of PU Powder Material
4.8. Assessment of A. mediterranei ISP5501 Esterase and Proteinase Activities
4.9. A. mediterranei ISP5501 Whole-Genome Sequencing, Genome Assembly, and Annotation
Supplementary Materials
Author Contributions
Funding
Data Availability Statement
Conflicts of Interest
References
- Liu, J.; He, J.; Xue, R.; Xu, B.; Qian, X.; Xin, F.; Blank, L.M.; Zhou, J.; Wei, R.; Dong, W. Biodegradation and up-cycling of polyurethanes: Progress, challenges, and prospects. Biotechnol. Adv. 2021, 48, 107730. [Google Scholar] [CrossRef] [PubMed]
- Mordorinteligence. Polyurethane Market—Growth, Trends, COVID-19 Impact, and Forecasts (2022–2027). 2021. Available online: https://www.reportlinker.com/p06316155/Polyurethane-Market-Growth-Trends-COVID-19-Impact-and-Forecasts.html?utm_source=GNW (accessed on 28 September 2022).
- Zhang, Y.-Q.; Lykaki, M.; Markiewicz, M.; Alrajoula, M.T.; Kraas, C.; Stolte, S. Environmental contamination by microplastics originating from textiles: Emission, transport, fate and toxicity. J. Haz. Mat. 2022, 430, 128453. [Google Scholar] [CrossRef] [PubMed]
- Liang, C.; Gracida-Alvarez, U.R.; Gallant, E.T.; Gillis, P.A.; Marques, Y.A.; Abramo, G.P.; Hawkins, T.R.; Dunn, J.B. Material flows of polyurethane in the United States. Environ. Sci. Technol. 2021, 55, 14215–14224. [Google Scholar] [CrossRef]
- Esperanza, M.; Font, R.; GarcíA, A. Toxic byproducts from the combustion of varnish wastes based on polyurethane in a laboratory furnace. J. Haz. Mat. 2000, 77, 107–121. [Google Scholar] [CrossRef]
- Gadhave, R.V.; Srivastava, S.; Mahanwar, P.A.; Gadekar, P.T. Recycling and disposal methods for polyurethane wastes: A review. Open J. Polymer Chem. 2019, 9, 39–51. [Google Scholar] [CrossRef]
- Zimmermann, L.; Dierkes, G.; Ternes, T.A.; VöLker, C.; Wagner, M. Benchmarking the in vitro toxicity and chemical composition of plastic consumer products. Environ. Sci. Technol. 2019, 53, 11467–11477. [Google Scholar] [CrossRef] [PubMed]
- Yuan, Z.; Nag, R.; Cummins, E. Ranking of potential hazards from microplastics polymers in the marine environment. J. Haz. Mat. 2022, 429, 128399. [Google Scholar] [CrossRef]
- Oz, K.; Merav, B.; Sara, S.; Yael, D. Volatile organic compound emissions from polyurethane mattresses under variable environmental conditions. Environ. Sci. Technol. 2019, 53, 9171–9180. [Google Scholar] [CrossRef]
- Garrido, M.A.; Gerecke, A.C.; Heeb, N.; Font, R.; Conesa, J.A. Isocyanate emissions from pyrolysis of mattresses containing polyurethane foam. Chemosphere 2017, 168, 667–675. [Google Scholar] [CrossRef]
- Luft, A.; BröDer, K.; Kunkel, U.; Schulz, M.; Dietrich, C.; Baier, R.; Heininger, P.; Ternes, T.A. Nontarget analysis via LC-QTOF-MS to assess the release of organic substances from polyurethane coating. Environ. Sci. Technol. 2017, 51, 9979–9988. [Google Scholar] [CrossRef]
- Ibarra, J.C.; Uscátegui, Y.L.; Arévalo, F.R.; Díaz, L.E.; Valero, M.F. Influence of diisocyanate chemical structure on the properties, degradation and cytotoxicity of polyurethanes obtained from castor oil. J. Biomat. Tissue Eng. 2018, 8, 279–289. [Google Scholar] [CrossRef]
- Simón, D.; Borreguero, A.; De Lucas, A.; Rodríguez, J. Recycling of polyurethanes from laboratory to industry, a journey towards the sustainability. Waste Manag. 2018, 76, 147–171. [Google Scholar] [CrossRef] [PubMed]
- Marson, A.; Masiero, M.; Modesti, M.; Scipioni, A.; Manzardo, A. Life Cycle Assessment of polyurethane foams from polyols obtained through chemical recycling. ACS Omega 2021, 6, 1718–1724. [Google Scholar] [CrossRef]
- Tournier, V.; Topham, C.; Gilles, A.; David, B.; Folgoas, C.; Moya-Leclair, E.; Kamionka, E.; Desrousseaux, M.-L.; Texier, H.; Gavalda, S. An engineered PET depolymerase to break down and recycle plastic bottles. Nature 2020, 580, 216–219. [Google Scholar] [CrossRef]
- Jin, X.; Dong, J.; Guo, X.; Ding, M.; Bao, R.; Luo, Y. Current advances in polyurethane biodegradation. Polym. Int. 2022, 71, 1384–1392. [Google Scholar] [CrossRef]
- Mahajan, N.; Gupta, P. New insights into the microbial degradation of polyurethanes. RSC Adv. 2015, 5, 41839–41854. [Google Scholar] [CrossRef]
- Skleničková, K.; Abbrent, S.; Halecký, M.; Kočí, V.; Beneš, H. Biodegradability and ecotoxicity of polyurethane foams: A review. Crit. Rev. Environ. Sci. Technol. 2020, 52, 157–202. [Google Scholar] [CrossRef]
- Magnin, A.; Entzmann, L.; Pollet, E.; Avérous, L. Breakthrough in polyurethane bio-recycling: An efficient laccase-mediated system for the degradation of different types of polyurethanes. Waste Manag. 2021, 132, 23–30. [Google Scholar] [CrossRef]
- Nakajima-Kambe, T.; Onuma, F.; Akutsu, Y.; Nakahara, T. Determination of the polyester polyurethane breakdown products and distribution of the polyurethane degrading enzyme of Comamonas acidovorans strain TB-35. J. Ferment. Bioeng. 1997, 83, 456–460. [Google Scholar] [CrossRef]
- PAZy—The Plastics-Active Enzymes Database. Available online: https://pazy.eu/doku.php (accessed on 22 July 2022).
- Buchholz, P.; Zhang, H.; Perez-Garcia, P.; Nover, L.-L.; Chow, J.; Streit, W.R.; Pleiss, J. Plastics degradation by hydrolytic enzymes: The Plastics-Active Enzymes Database-PAZy. Proteins 2021, 90, 1443–1456. [Google Scholar] [CrossRef]
- Magnin, A.; Pollet, E.; Phalip, V.; Avérous, L. Evaluation of biological degradation of polyurethanes. Biotechnol. Advan. 2020, 39, 107457. [Google Scholar] [CrossRef]
- Magnin, A.; Pollet, E.; Perrin, R.; Ullmann, C.; Persillon, C.; Phalip, V.; Avérous, L. Enzymatic recycling of thermoplastic polyurethanes: Synergistic effect of an esterase and an amidase and recovery of building blocks. Waste Manag. 2019, 85, 141–150. [Google Scholar] [CrossRef]
- Liu, J.; Liu, J.; Xu, B.; Xu, A.; Cao, S.; Wei, R.; Zhou, J.; Jiang, M.; Dong, W. Biodegradation of polyether-polyurethane foam in yellow mealworms (Tenebrio molitor) and effects on the gut microbiome. Chemosphere 2022, 304, 135263. [Google Scholar] [CrossRef]
- Chow, J.; Perez-Garcia, P.; Dierkes, R.; Streit, W.R. Microbial enzymes will offer limited solutions to the global plastic pollution crisis. Microb. Biotechnol. 2023, 16, 195–217. [Google Scholar] [CrossRef] [PubMed]
- Zhang, K.; Hu, J.; Yang, S.; Xu, W.; Wang, Z.; Zhuang, P.; Grossart, H.-P.; Luo, Z. Biodegradation of polyester polyurethane by the marine fungus Cladosporium halotolerans 6UPA1. J. Haz. Mat. 2022, 437, 129406. [Google Scholar] [CrossRef]
- Howard, G.; Vicknair, J.; Mackie, R. Sensitive plate assay for screening and detection of bacterial polyurethanase activity. Lett. Appl. Microbiol. 2001, 32, 211–214. [Google Scholar] [CrossRef]
- Biffinger, J.C.; Barlow, D.E.; Cockrell, A.L.; Cusick, K.D.; Hervey, W.J.; Fitzgerald, L.A.; Nadeau, L.J.; Hung, C.S.; Crookes-Goodson, W.J.; Russell, J.N., Jr. The applicability of Impranil® DLN for gauging the biodegradation of polyurethanes. Polym. Degrad. Stabil. 2015, 120, 178–185. [Google Scholar] [CrossRef]
- Islam, S.; Apitius, L.; Jakob, F.; Schwaneberg, U. Targeting microplastic particles in the void of diluted suspensions. Environ. Int. 2019, 123, 428–435. [Google Scholar] [CrossRef] [PubMed]
- Gamerith, C.; Acero, E.H.; Pellis, A.; Ortner, A.; Vielnascher, R.; Luschnig, D.; Zartl, B.; Haernvall, K.; Zitzenbacher, S.; Strohmeier, G. Improving enzymatic polyurethane hydrolysis by tuning enzyme sorption. Polym. Degrad. Stabil. 2016, 132, 69–77. [Google Scholar] [CrossRef]
- Nishio, A.; Mochizuki, A.; Sugiyama, J.I.; Takeuchi, K.; Asai, M.; Yonetake, K.; Ueda, M. Synthesis and characterization of ordered polyurethanes from nonsymmetric diisocyanate and ethylene glycol. J. Polym. Sci. A Polym. Chem. 2000, 38, 2106–2114. [Google Scholar] [CrossRef]
- Hikita, T.; Mochizuki, A.; Sugiyama, J.-I.; Takeuchi, K.; Asai, M.; Ueda, M. Head-to-tail regularity of polyurethanes from p-isocyanatobenzyl isocyanate and ethylene glycol by a distannoxane catalyst. Polym. J. 2001, 33, 547–553. [Google Scholar] [CrossRef]
- Chambers, J.; Reese, C.B. The thermal decomposition of some tolylene bis-carbamates. Brit. Polym. J. 1977, 9, 41–46. [Google Scholar] [CrossRef]
- Lubczak, R.; Lubczak, J. Reactions of hydroxyalkyl esters with phenyl isocyanate. J. Appl. Polym. Sci. 2005, 96, 1357–1367. [Google Scholar] [CrossRef]
- Utomo, R.N.C.; Li, W.-J.; Tiso, T.; Eberlein, C.; Doeker, M.; Heipieper, H.J.; Jupke, A.; Wierckx, N.; Blank, L.M. Defined microbial mixed culture for utilization of polyurethane monomers. ACS Sust. Chem. Eng. 2020, 8, 17466–17474. [Google Scholar] [CrossRef]
- Mishra, S.; Pang, S.; Zhang, W.; Lin, Z.; Bhatt, P.; Chen, S. Insights into the microbial degradation and biochemical mechanisms of carbamates. Chemosphere 2021, 279, 130500. [Google Scholar] [CrossRef]
- Amato-Lourenço, L.F.; Carvalho-Oliveira, R.; Júnior, G.R.; Dos Santos Galvão, L.; Ando, R.A.; Mauad, T. Presence of airborne microplastics in human lung tissue. J. Haz. Mat. 2021, 416, 126124. [Google Scholar] [CrossRef]
- Neale, P.A.; Antony, A.; Bartkow, M.E.; Farre, M.J.; Heitz, A.; Kristiana, I.; Tang, J.Y.; Escher, B.I. Bioanalytical assessment of the formation of disinfection byproducts in a drinking water treatment plant. Environ. Sci. Technol. 2012, 46, 10317–10325. [Google Scholar] [CrossRef]
- Ventura, S.P.; De Morais, P.; Coelho, J.A.; Sintra, T.; Coutinho, J.A.; Afonso, C.A. Evaluating the toxicity of biomass derived platform chemicals. Green Chem. 2016, 18, 4733–4742. [Google Scholar] [CrossRef]
- Dodard, S.; Renoux, A.; Hawari, J.; Ampleman, G.; Thiboutot, S.; Sunahara, G. Ecotoxicity characterization of dinitrotoluenes and some of their reduced metabolites. Chemosphere 1999, 38, 2071–2079. [Google Scholar] [CrossRef]
- Šepič, E.; Bricelj, M.; Leskovšek, H. Toxicity of fluoranthene and its biodegradation metabolites to aquatic organisms. Chemosphere 2003, 52, 1125–1133. [Google Scholar] [CrossRef]
- Zimmermann, L.; Göttlich, S.; Oehlmann, J.; Wagner, M.; Völker, C. What are the drivers of microplastic toxicity? Comparing the toxicity of plastic chemicals and particles to Daphnia magna. Environ. Pollut. 2020, 267, 115392. [Google Scholar] [CrossRef] [PubMed]
- Wittkowski, P.; Marx-Stoelting, P.; Violet, N.; Fetz, V.; Schwarz, F.; OelgeschläGer, M.; SchöNfelder, G.; Vogl, S. Caenorhabditis elegans as a promising alternative model for environmental chemical mixture effect assessment—A comparative study. Environ. Sci. Technol. 2019, 53, 12725–12733. [Google Scholar] [CrossRef]
- Judy, J.D.; Williams, M.; Gregg, A.; Oliver, D.; Kumar, A.; Kookana, R.; Kirby, J.K. Microplastics in municipal mixed-waste organic outputs induce minimal short to long-term toxicity in key terrestrial biota. Environ. Pollut. 2019, 252, 522–531. [Google Scholar] [CrossRef]
- Mcqueen, C.A.; Williams, G.M. Review of the genotoxicity and carcinogenicity of 4, 4′-methylene-dianiline and 4, 4′-methylene-bis-2-chloroaniline. Mutat. Res./Rev. Gen. Toxicol. 1990, 239, 133–142. [Google Scholar] [CrossRef] [PubMed]
- Cregut, M.; Bedas, M.; Durand, M.-J.; Thouand, G. New insights into polyurethane biodegradation and realistic prospects for the development of a sustainable waste recycling process. Biotechnol. Adv. 2013, 31, 1634–1647. [Google Scholar] [CrossRef] [PubMed]
- Diefenbach, X.W.; Farasat, I.; Guetschow, E.D.; Welch, C.J.; Kennedy, R.T.; Sun, S.; Moore, J.C. Enabling biocatalysis by high-throughput protein engineering using droplet microfluidics coupled to mass spectrometry. ACS Omega 2018, 3, 1498–1508. [Google Scholar] [CrossRef]
- Djapovic, M.; Milivojevic, D.; Ilic-Tomic, T.; Lješević, M.; Nikolaivits, E.; Topakas, E.; Maslak, V.; Nikodinovic-Runic, J. Synthesis and characterization of polyethylene terephthalate (PET) precursors and potential degradation products: Toxicity study and application in discovery of novel PETases. Chemosphere 2021, 275, 130005. [Google Scholar] [CrossRef]
- Yue, W.; Yin, C.-F.; Sun, L.; Zhang, J.; Xu, Y.; Zhou, N.-Y. Biodegradation of bisphenol-A polycarbonate plastic by Pseudoxanthomonas sp. strain NyZ600. J. Haz. Mat. 2021, 416, 125775. [Google Scholar] [CrossRef]
- Labow, R.S.; Meek, E.; Santerre, J.P. The biodegradation of poly (urethane) s by the esterolytic activity of serine proteases and oxidative enzyme systems. J. Biomat. Sci. 1999, 10, 699–713. [Google Scholar] [CrossRef]
- Gololobov, M.Y.; Morozova, I.P.; Vojushina, T.L.; Timokhina, E.A.; Stepanov, V.M. Subtilisin from Bacillus subtilis strain 72. The influence of substrate structure, temperature and pH on catalytic properties. Biochim. Biophys. Acta 1992, 1118, 267–276. [Google Scholar] [CrossRef]
- Spasic, J.; Mandic, M.; Djokic, L.; Nikodinovic-Runic, J. Streptomyces spp. in the biocatalysis toolbox. Appl. Microbiol. Biotechnol. 2018, 102, 3513–3536. [Google Scholar] [CrossRef] [PubMed]
- Molitor, R.; Bollinger, A.; Kubicki, S.; Loeschcke, A.; Jaeger, K.E.; Thies, S. Agar plate-based screening methods for the identification of polyester hydrolysis by Pseudomonas species. Microb. Biotechnol. 2020, 13, 274–284. [Google Scholar] [CrossRef]
- Singhvi, N.; Singh, P.; Prakash, O.; Gupta, V.; Lal, S.; Bechthold, A.; Singh, Y.; Singh, R.K.; Lal, R. Differential mass spectrometry-based proteome analyses unveil major regulatory hubs in rifamycin B production in Amycolatopsis mediterranei. J. Proteom. 2021, 239, 104168. [Google Scholar] [CrossRef]
- Pranamuda, H.; Tokiwa, Y. Degradation of poly (L-lactide) by strains belonging to genus Amycolatopsis. Biotechnol. Lett. 1999, 21, 901–905. [Google Scholar] [CrossRef]
- Gambarini, V.; Pantos, O.; Kingsbury, J.M.; Weaver, L.; Handley, K.M.; Lear, G. Phylogenetic distribution of plastic-degrading microorganisms. Msystems 2021, 6, e01112–e01120. [Google Scholar] [CrossRef] [PubMed]
- Joo, S.; Cho, I.J.; Seo, H.; Son, H.F.; Sagong, H.-Y.; Shin, T.J.; Choi, S.Y.; Lee, S.Y.; Kim, K.-J. Structural insight into molecular mechanism of poly (ethylene terephthalate) degradation. Nat. Comm. 2018, 9, 382. [Google Scholar] [CrossRef]
- Christenson, E.M.; Patel, S.; Anderson, J.M.; Hiltner, A. Enzymatic degradation of poly (ether urethane) and poly (carbonate urethane) by cholesterol esterase. Biomaterials 2006, 27, 3920–3926. [Google Scholar] [CrossRef]
- Loredo-Treviño, A.; Gutiérrez-Sánchez, G.; Rodríguez-Herrera, R.; Aguilar, C.N. Microbial enzymes involved in polyurethane biodegradation: A review. J. Polym. Environ. 2012, 20, 258–265. [Google Scholar] [CrossRef]
- Wei, R.; Zimmermann, W. Microbial enzymes for the recycling of recalcitrant petroleum-based plastics: How far are we? Microb. Biotechnol. 2017, 10, 1308–1322. [Google Scholar] [CrossRef]
- Puiggené, Ò.; Espinosa, M.J.C.; Schlosser, D.; Thies, S.; Jehmlich, N.; Kappelmeyer, U.; Schreiber, S.; Wibberg, D.; Kalinowski, J.; Harms, H. Extracellular degradation of a polyurethane oligomer involving outer membrane vesicles and further insights on the degradation of 2, 4-diaminotoluene in Pseudomonas capeferrum TDA1. Sci. Rep. 2022, 12, 1–12. [Google Scholar] [CrossRef]
- Shah, Z.; Krumholz, L.; Aktas, D.F.; Hasan, F.; Khattak, M.; Shah, A.A. Degradation of polyester polyurethane by a newly isolated soil bacterium, Bacillus subtilis strain MZA-75. Biodegradation 2013, 24, 865–877. [Google Scholar] [CrossRef] [PubMed]
- Magnin, A.; Hoornaert, L.; Pollet, E.; Laurichesse, S.; Phalip, V.; Avérous, L. Isolation and characterization of different promising fungi for biological waste management of polyurethanes. Microb. Biotechnol. 2019, 12, 544–555. [Google Scholar] [CrossRef]
- Wei, R.; Oeser, T.; Then, J.; Kühn, N.; Barth, M.; Schmidt, J.; Zimmermann, W. Functional characterization and structural modeling of synthetic polyester-degrading hydrolases from Thermomonospora curvata. AMB Express 2014, 4, 44. [Google Scholar] [CrossRef]
- Bauer, T.L.; Buchholz, P.C.; Pleiss, J. The modular structure of α/β-hydrolases. FEBS J. 2020, 287, 1035–1053. [Google Scholar] [CrossRef] [PubMed]
- Tan, Y.; Henehan, G.T.; Kinsella, G.K.; Ryan, B.J. An extracellular lipase from Amycolatopsis mediterannei is a cutinase with plastic degrading activity. Comp. Struct. Biotechnol. J. 2021, 19, 869–879. [Google Scholar] [CrossRef] [PubMed]
- Schupp, T.; Toupet, C.; Engel, N.; Goff, S. Cloning and sequence analysis of the putative rifamycin polyketide synthase gene cluster from Amycolatopsis mediterranei. FEMS Microb. Lett. 1998, 159, 201–267. [Google Scholar] [CrossRef]
- Chek, M.F.; Hiroe, A.; Hakoshima, T.; Sudesh, K.; Taguchi, S. PHA synthase (PhaC): Interpreting the functions of bioplastic-producing enzyme from a structural perspective. Appl. Microbiol. Biotechnol. 2019, 103, 1131–1141. [Google Scholar] [CrossRef]
- Dimarogona, M.; Nikolaivits, E.; Kanelli, M.; Christakopoulos, P.; Sandgren, M.; Topakas, E. Structural and functional studies of a Fusarium oxysporum cutinase with polyethylene terephthalate modification potential. Biochim. Biophys. Acta-Gen. Subj. 2015, 1850, 2308–2317. [Google Scholar] [CrossRef]
- Ronkvist, Å.M.; Xie, W.; Lu, W.; Gross, R.A. Cutinase-catalyzed hydrolysis of poly (ethylene terephthalate). Macromolecules 2009, 42, 5128–5138. [Google Scholar] [CrossRef]
- Shigeno-Akutsu, Y.; Nakajima-Kambe, T.; Nomura, N.; Nakahara, T. Purification and properties of culture-broth-secreted esterase from the polyurethane degrader Comamonas acidovorans TB-35. J. Biosci. Bioeng. 1999, 88, 484–487. [Google Scholar] [CrossRef]
- Yoshida, S.; Hiraga, K.; Takehana, T.; Taniguchi, I.; Yamaji, H.; Maeda, Y.; Toyohara, K.; Miyamoto, K.; Kimura, Y.; Oda, K. A bacterium that degrades and assimilates poly (ethylene terephthalate). Science 2016, 351, 1196–1199. [Google Scholar] [CrossRef] [PubMed]
- Kumar, S.; Stecher, G.; Li, M.; Knyaz, C.; Tamura, K. MEGA X: Molecular evolutionary genetics analysis across computing platforms. Molec. Biol. Evol. 2018, 35, 1547. [Google Scholar] [CrossRef]
- Espinosa, M.; Blanco, A.; Schmidgall, T.; Atanasoff-Kardjalieff, A.; Kappelmeyer, U.; Tischler, D.; Pieper, D.; Heipieper, H.; Eberlein, C. Toward biorecycling: Isolation of a soil bacterium that grows on a polyurethane oligomer and monomer. Front. Microbiol. 2020, 11, 404. [Google Scholar] [CrossRef]
- Nikolaivits, E.; Taxeidis, G.; Gkountela, C.; Vouyiouka, S.; Maslak, V.; Nikodinovic-Runic, J.; Topakas, E. A polyesterase from the Antarctic bacterium Moraxella sp. degrades highly crystalline synthetic polymers. J. Haz. Mat. 2022, 434, 128900. [Google Scholar] [CrossRef]
- Samal, B.B.; Karan, B.; Stabinsky, Y. Stability of two novel serine proteinases in commercial laundry detergent formulations. Biotechnol. Bioeng. 1990, 35, 650–652. [Google Scholar] [CrossRef]
- Goldie, J.; Veldhuyzen Van Zanten, S.; Jalali, S.; Hollingsworth, J.; Riddell, R.; Richardson, H.; Hunt, R. Optimization of a medium for the rapid urease test for detection of Campylobacter pylori in gastric antral biopsies. J. Clin. Microbiol. 1989, 27, 2080–2082. [Google Scholar] [CrossRef] [PubMed]
- Tanaka, T.; Kawase, M.; Tani, S. Urease inhibitory activity of simple α, β-unsaturated ketones. Life Sci 2003, 73, 2985–2990. [Google Scholar] [CrossRef] [PubMed]
- Lowry, O.; Rosebrough, N.; Farr, A.; Randall, R. Protein measurement with the Folin phenol reagent. J. Biol. Chem. 1951, 193, 265–275. [Google Scholar] [CrossRef] [PubMed]
- Martin, M. Cutadapt removes adapter sequences from high-throughput sequencing reads. EMBnet J. 2011, 17, 10–12. [Google Scholar] [CrossRef]
- Bankevich, A.; Nurk, S.; Antipov, D.; Gurevich, A.A.; Dvorkin, M.; Kulikov, A.S.; Lesin, V.M.; Nikolenko, S.I.; Pham, S.; Prjibelski, A.D. SPAdes: A new genome assembly algorithm and its applications to single-cell sequencing. J. Comp. Biol. 2012, 19, 455–477. [Google Scholar] [CrossRef]
- Manni, M.; Berkeley, M.R.; Seppey, M.; Simão, F.A.; Zdobnov, E.M. BUSCO update: Novel and streamlined workflows along with broader and deeper phylogenetic coverage for scoring of eukaryotic, prokaryotic, and viral genomes. Molec. Biol. Evol. 2021, 38, 4647–4654. [Google Scholar] [CrossRef] [PubMed]
- Li, W.; O’neill, K.R.; Haft, D.H.; Dicuccio, M.; Chetvernin, V.; Badretdin, A.; Coulouris, G.; Chitsaz, F.; Derbyshire, M.K.; Durkin, A.S. RefSeq: Expanding the prokaryotic genome annotation pipeline reach with protein family model curation. Nucleic Acids Res. 2021, 49, D1020–D1028. [Google Scholar] [CrossRef]
- Blin, K.; Shaw, S.; Kloosterman, A.M.; Charlop-Powers, Z.; Van Wezel, G.P.; Medema, M.H.; Weber, T. antiSMASH 6.0: Improving cluster detection and comparison capabilities. Nucleic Acids Res. 2021, 49, W29–W35. [Google Scholar] [CrossRef]
- Kanehisa, M.; Sato, Y.; Morishima, K. BlastKOALA and GhostKOALA: KEGG tools for functional characterization of genome and metagenome sequences. J. Mol. Biol. 2016, 428, 726–731. [Google Scholar] [CrossRef] [PubMed]
- Grasso, S.; Van Rij, T.; Van Dijl, J.M. GP4: An integrated Gram-positive protein prediction pipeline for subcellular localization mimicking bacterial sorting. Brief Bioinformat. 2021, 22, bbaa302. [Google Scholar] [CrossRef] [PubMed]
- Hallgren, J.; Tsirigos, K.D.; Pedersen, M.D.; Armenteros, J.J.A.; Marcatili, P.; Nielsen, H.; Krogh, A.; Winther, O. DeepTMHMM predicts alpha and beta transmembrane proteins using deep neural networks. bioRxiv 2022. [Google Scholar] [CrossRef]
- Biocatnet, The Lipase Engineering Database (LED). Available online: http://www.led.uni-stuttgart.de/ (accessed on 25 July 2022).

| Mn (g mol−1) | Mw (g mol−1) | PDI a | |
|---|---|---|---|
| Initial material | 86,583 ± 50 | 146,755 ± 10 | 1.69 ± 0.01 |
| Control culture | 83,621 ± 39 | 144,835 ± 2772 | 1.73 ± 0.06 |
| Whole cells (PU) | 80,500 ± 781 | 145,065 ± 202 | 1.80 ± 0.01 |
| Whole cells (PU + Impranil) | 74,933 ± 279 | 146,159 ± 1219 | 1.95 ± 0.02 |
| Mn (g mol−1) | Mw (g mol−1) | PDI a | |
|---|---|---|---|
| Initial material | 86,583 ± 50 | 146,755 ± 10 | 1.69 ± 0.01 |
| Control (Tris buffer) | 88,382 ± 760 | 147,263 ± 1263 | 1.67 ± 0.05 |
| Extracellular fraction | 84,824 ± 186 | 148,841 ± 1133 | 1.75 ± 0.02 |
| Intracellular fraction | 77,364 ± 274 | 146,227 ± 248 | 1.89 ± 0.01 |
| Mixed fraction | 78,170 ± 28 | 146,603 ± 249 | 1.88 ± 0.01 |
| Enzyme Family | Intracellular | Membrane-Bound | Extracellular |
|---|---|---|---|
| Amidases | 70 | 3 | 14 |
| Esterases | 88 | 9 | 64 |
| Other α/β hydrolases | 123 | 6 | 17 |
| Proteases | 199 | 68 | 120 |
| Ureases | 9 | 0 | 0 |
Disclaimer/Publisher’s Note: The statements, opinions and data contained in all publications are solely those of the individual author(s) and contributor(s) and not of MDPI and/or the editor(s). MDPI and/or the editor(s) disclaim responsibility for any injury to people or property resulting from any ideas, methods, instructions or products referred to in the content. |
© 2023 by the authors. Licensee MDPI, Basel, Switzerland. This article is an open access article distributed under the terms and conditions of the Creative Commons Attribution (CC BY) license (https://creativecommons.org/licenses/by/4.0/).
Share and Cite
Pantelic, B.; Skaro Bogojevic, S.; Milivojevic, D.; Ilic-Tomic, T.; Lončarević, B.; Beskoski, V.; Maslak, V.; Guzik, M.; Makryniotis, K.; Taxeidis, G.; et al. Set of Small Molecule Polyurethane (PU) Model Substrates: Ecotoxicity Evaluation and Identification of PU Degrading Biocatalysts. Catalysts 2023, 13, 278. https://doi.org/10.3390/catal13020278
Pantelic B, Skaro Bogojevic S, Milivojevic D, Ilic-Tomic T, Lončarević B, Beskoski V, Maslak V, Guzik M, Makryniotis K, Taxeidis G, et al. Set of Small Molecule Polyurethane (PU) Model Substrates: Ecotoxicity Evaluation and Identification of PU Degrading Biocatalysts. Catalysts. 2023; 13(2):278. https://doi.org/10.3390/catal13020278
Chicago/Turabian StylePantelic, Brana, Sanja Skaro Bogojevic, Dusan Milivojevic, Tatjana Ilic-Tomic, Branka Lončarević, Vladimir Beskoski, Veselin Maslak, Maciej Guzik, Konstantinos Makryniotis, George Taxeidis, and et al. 2023. "Set of Small Molecule Polyurethane (PU) Model Substrates: Ecotoxicity Evaluation and Identification of PU Degrading Biocatalysts" Catalysts 13, no. 2: 278. https://doi.org/10.3390/catal13020278
APA StylePantelic, B., Skaro Bogojevic, S., Milivojevic, D., Ilic-Tomic, T., Lončarević, B., Beskoski, V., Maslak, V., Guzik, M., Makryniotis, K., Taxeidis, G., Siaperas, R., Topakas, E., & Nikodinovic-Runic, J. (2023). Set of Small Molecule Polyurethane (PU) Model Substrates: Ecotoxicity Evaluation and Identification of PU Degrading Biocatalysts. Catalysts, 13(2), 278. https://doi.org/10.3390/catal13020278

